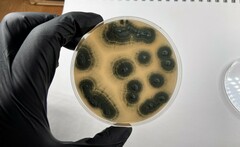
Penicillium roqueforti
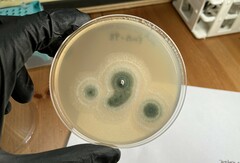
Penicillium roqueforti
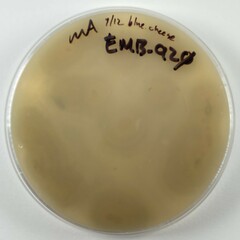
Penicillium roqueforti
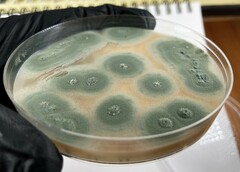
Penicillium roqueforti
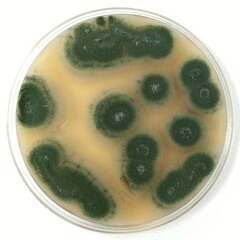
Penicillium roqueforti
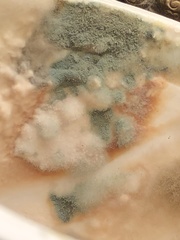
Penicillium roqueforti

Penicillium roqueforti: taxon details and analytics
- Domain
- Kingdom
- Fungi
- Phylum
- Ascomycota
- Class
- Eurotiomycetes
- Order
- Eurotiales
- Family
- Aspergillaceae
- Genus
- Penicillium
- Species
- Penicillium roqueforti
- Scientific Name
- Penicillium roqueforti
Summary description from Wikipedia:
Penicillium roqueforti
Penicillium roqueforti is a common saprotrophic fungus in the genus Penicillium. Widespread in nature, it can be isolated from soil, decaying organic matter, and plants.
The major industrial uses of this fungus are the production of blue cheeses, flavouring agents, antifungals, polysaccharides, proteases, and other enzymes. The fungus has been a constituent of Roquefort, Stilton, Danish blue, Cabrales, and other blue cheeses. A few blue cheeses, such as Gorgonzola, are made instead with Penicillium glaucum.
...Penicillium roqueforti in languages:
- Czech
- štětičkovec roquefortský
Images from inaturalist.org observations:
We recommend you sign up for this excellent, free service.